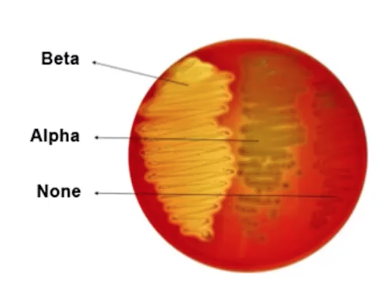

What are prokaryotes?
- archaea
- bacteria
What are eukaryotes?
- eucarya
- (nucleated, organelles)
What are some examples of distinguishing features of bacteria?
- morphology
- microscopy
- colony
- staining characteristics (gram)
- growth requirements
- toxin and enzyme production
- response to phages or antimicrobials
- presence/ absence of surface/ antigenic structures
How do bacteria replicate?
- binary fission
- haploid
- DNA is replicated
- then the cell membrane is elongated and the 2 DNA molecules separated
- cell wall forms and cell membrane invaginates
- cross wall forms completely
- then get 2 daughter cells
What are the different phases in the growth curve?
- lag phase - preparing for the exponential growth
- log phase - bacteria divide as quickly as they can
- stationary phase - growth is equal to death - nutrients are depleting
- death phase - die due to no nutrients left/ oxygen used up
- long-term stationary - not all die
What are the categories of bacteria?
- bacilli - rods
- cocci - spherical
- staphylococci - bunch of grapes
- streptococci - long line
- spirochaetes
- vibrios - comma


How are endospores formed?
- DNA replication in vegetative cell
- DNA lines up along long axis
- cell membrane invaginates inside to form forespore
- the cell membrane grows and engulfs the forespore in a secondary membrane
- vegetative DNA disintergrates
- a cortex of calcium and diplicolinic acid is deposited between membranes
- spore coat forms around endospore
- maturation of endospore - completion of spore coat - increased resistance to heat etc.
- endospore released from cell
What are the different bacteria staining techniques?
- Gram staining
- +ve/-ve
- based to crystal violet staining and counterstaining
- heat fixation
- Diff Quick
- rapid - morphology
- wet fixation
- Specific
- ZN - mycobacteria
- silver - spirochaetes
How is gram staining done?
- heat fixation
- crystal violet - stains everything (peptidoglycan)
- iodine - traps the cv in cell - stays in the gram +ve cells
- alcohol wash - washes cv out of gram -ve cells - but it is trapped in the gram +ve due to iodine
- safranin - counterstaining - gram -ve = pink, gram +ve = purple
Why is staining different between gram +ve and -ve?
- gram +ve- have thick peptidoglycan layer and a single cell membrane - peptidoglycan binds cystal violet
- gram -ve - inner and outer protective membrane, thick peptidoglycan layer - no trapping of cv to peptidoglycan
Role of peptidoglycan?
- gives rigidity to bacterial cell
- assists in preventing phagocytosis
- pyrogenic properties (fever)
- degraded by lysozyme
How to do Diff quick staining?
- one drop on slide - allow to air dry briefly
- place in fixative
- solution 1
- solution 2
- distilled water wash
What are the different types of growth media?
- nutrient media (slower growth)
- nutrient agar
- Mueller Hinton
- enriched media - fastidious organisms
- blood/ serum agar (whole blood, lysed blood, serum)
- electron acdeptors, energy sources
- selective media
- supplemented plates e.g. antibiotics (camp)
- differential use of nutrients (fermentation of sugars)
- MacConkey agar
Name the gas conditions
- oxygen
- aerobic
- facultative anaerobic - survive in both but sometimes will need electron acceptors to survive without oxygen
- microaerobic - camp
- co2
- all organisms
- capnophiles - >5%
- hydrogen
What are the optimal temps for listeria and thermophilic campylobacter spp?
- 4 degrees
- 42 degrees
What is the oxidase test? which bacterium are +ve/ -ve?
- testing for gram -ve bacteria
- based on cytochrome C oxidase
- +ve = moraxella, Neisseria, Campy, Pseudomonas = dark purple
- -ve = Enterobacteriaceae = stay white/ yellow
What is the catalase test?
- tests the conversion from H2O2 to H2O and O2
- bubbles
- +ve = staphylococcus, listeria, enterobacteriaceae
- -ve = streptococcus, enterococcus
What is the coagulase test?
- tests conversion of fibrinogen to fibrin
- see if insoluble material formed - if so +ve
- +ve = s.aureus, s.intermedius
- -ve = s. epidermis, s.hominis (CNS)
What is an API strip?
- enzymes and substrates
- multiple biochemical tests at once
What is MacConkey agar?
- selects for lactose fermenters
- senses pH - change with neutral red
- inhibits gram +ve growth with bile and cv
- if lactose fermenting = pink/red e.g. E.coli
- if not = yellow e.g. salmonella
How do you plate out?
- flame the loop

What are the different types of hemolysis?
- beta = complete
- alpha = partial
- gamma = none
What are the other typing methods used?
- hemolysis - may be host specific
- serology - based on antisera to surface structures
- flagella
- LPS/ LOS
- capsule
- phage -typing - susceptibility to panel of bacteriophages
- antimicrobial resistance


